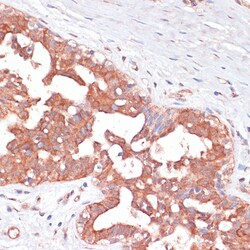
Invitrogen PGD Polyclonal Antibody 100 &mu;L | Buy Online | Invitrogen&trade; | Fisher Scientific

Learn More
Invitrogen™ PGD Polyclonal Antibody
Description
Immunogen sequence: KMVHNGIEYG DMQLICEAYH LMKDVLGMAQ DEMAQAFEDW NKTELDSFLI EITANILKFQ DTDGKHLLPK IRDSAGQKGT GKWTAISALE YGVPVTLIGE AVFARCLSSL KDERIQASKK LKGPQKFQFD GDKKSFLEDI RKALYASKII SYAQGFMLLR QAATEFGWTL NYGGIALMWR GGCIIRSVFL GKIKDAFDRN PELQNLLLDD FFKSAVENCQ DSWRRAVSTG VQAGIPMPCF TTALSFYDGY RHEMLPASLI QAQRDYFGAH TYELLAKPGQ FIHTNWTGHG GTVSSSSYNA; Positive Samples: A-549, 293T, Raji, Mouse kidney, Mouse lung, Mouse spleen, Rat kidney; Cellular Location: Cytoplasm.

Specifications
Specifications
| Antigen | PGD |
| Applications | ELISA, Immunohistochemistry (Paraffin), Western Blot, Immunocytochemistry |
| Classification | Polyclonal |
| Concentration | 1.3 mg/mL |
| Conjugate | Unconjugated |
| Formulation | PBS with 50% glycerol and 0.02% sodium azide; pH 7.3 |
| Gene | PGD |
| Gene Accession No. | P52209, P85968, Q9DCD0 |
| Gene Alias | 0610042A05Rik; 6PGD; 6-phosphogluconate dehydrogenase, decarboxylating; 6-phosphogluconate dehydrogenase, decarboxylating-like; AU019875; C78335; LOC100360180; Pgd; PGDH; phosphogluconate dehydrogenase |
| Gene Symbols | PGD |
| Show More |
By clicking Submit, you acknowledge that you may be contacted by Fisher Scientific in regards to the feedback you have provided in this form. We will not share your information for any other purposes. All contact information provided shall also be maintained in accordance with our Privacy Policy.